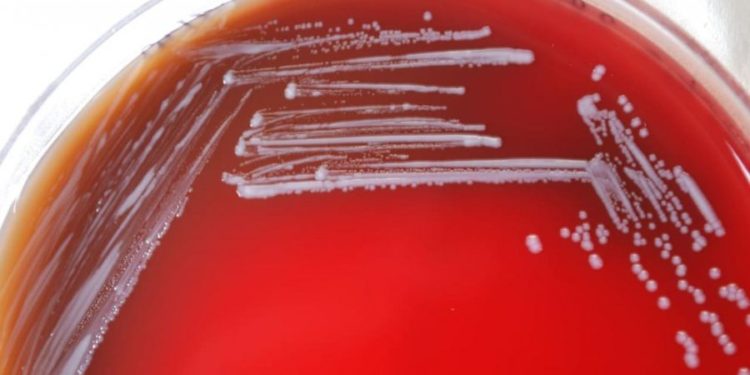
Gafë e rëndë në Kinë, bakteri i rrezikshëm del nga laboratori, infektohen mijëra njerëz

Nga BILD
Gafë e rëndë në Kinë: Bakteri i brucelës u arratis aksidentalisht nga një laborator kërkimor shtetëror, dhe, sipas informacioneve zyrtare, ka infektuar mijëra njerëz. Në qytetin e Lanzhoi, deri tani janë infektuar 3245 njerëz, thanë autoritetet shëndetësore. Sëmundja mund të shkaktojë ethe, dhimbje të kyçeve dhe të kokës. Shpesh ajo transmetohet nga kafshët e infektuara te njerëzit. Aktualisht nuk ka të dhëna për transmetimin e mundshëm nga njeriu te njeriu.
Në këtë rast, patogjeni erdhi nga një laborator shtetëror biofarmaceutike që prodhon vaksina për kafshët. Ngjarja ndodhi vitin e shkuar.
Bakteri hyri në sistemin e ventilimit
Laboratori thuhet se përdori dezinfektues të skaduar në prodhimin e flakonëve për vaksinat. Prandaj bakteri nuk u vra dhe u fut në sistemin e ventilimit të laboratorit. Era e përhapi patogjenin në institutin kërkimor veterinar, ku infektoi 200 persona që nga dhjetori.
Drejtoria e laboratorit kërkoi falje për incidentin. Siaps autoriteteve, ata e kanë humbur licencën për prodhimin e vaksinave. Të infektuarit do kompensohen duke nisur nga tetori.
Sipas ekspertëve, transmetimi i brucelozës nga njeriu te njeriu është shumë i rrallë. Në disa raste, patogjeni ngulitet përgjithmonë në organizmin njerëzor dhe shkakton simptoma të përjetshme si lodhje kronike, probleme të zemrës ose artrit.